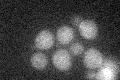
YGR029W
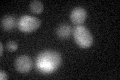
YGR029W

View description
Flavin-linked sulfhydryl oxidase of the mitochondrial intermembrane space (IMS), oxidizes Mia40p as part of a disulfide relay system that promotes IMS retention of imported proteins; ortholog of human hepatopoietin (ALR)
Localization:
Intensity:
Fold change:
Significance:
-
C’ GFP library in SD
below threshold16.46 -
N' NOP1pr-GFP in SD

mitochondria17.1106 -
N' TEF2pr-mCherry in SD

mitochondria5.80988 -
N' NATIVEpr-GFP in SD

mitochondria19.2354 -
N' TEF2pr-VC and Cyto-VN in SD

#N/A0 -
C’ GFP library in SD+DTT
cytosol17.291.05No -
C’ GFP library in SD+H2O2

cytosol14.650.89No -
C’ GFP library in Starvation Media

cytosol191.15No -
C’ GFP library on the background of Pup2-DaMP

below threshold -
C’ GFP library on the background of CCT mutant

below threshold16.20.98368No
